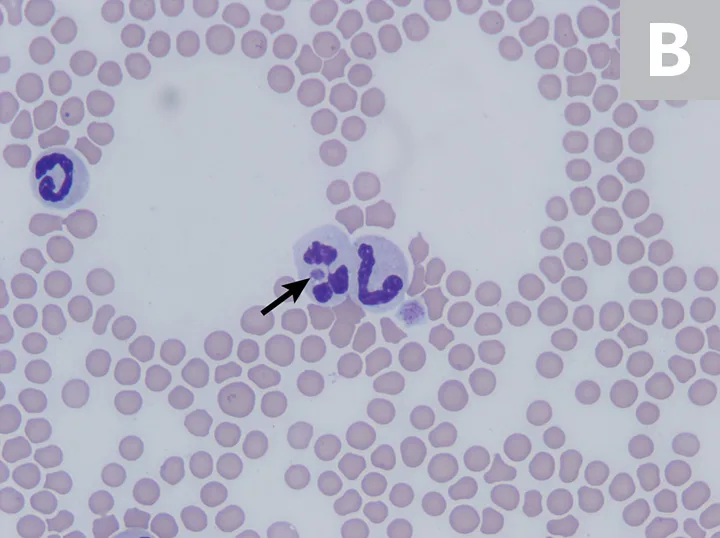
1A: Single neutrophil with arrow pointing to a small round purple-staining object within the cytoplasm. 1B: Three neutrophils, one with arrow pointing to a small round purple-staining object within the cytoplasm.

Granulocytic Anaplasmosis
Christine Savidge, DVM, DACVIM, Atlantic Veterinary College, Charlottetown, Prince Edward Island

Granulocytic anaplasmosis, an acute disease that affects dogs, cats, and other mammals, results from infection with the bacterium Anaplasma phagocytophilum and is transmitted primarily by the bite of an Ixodes spp tick.
Exposure is most prominent in areas endemic for Ixodes spp.1-6 Most dogs and cats exposed to A phagocytophilum do not develop clinical signs, but animals that do develop clinical disease often show nonspecific signs of lethargy, fever, and decreased appetite.2,7
Although there are several species in the Anaplasmataceae family that can cause anaplasmosis, this article focuses on A phagocytophilum.
Background & Pathophysiology
A phagocytophilum, a gram-negative intracellular bacterium, infects neutrophils and, occasionally, eosinophils in a variety of mammals, including dogs and cats.1,8 Although the organism is primarily vector-transmitted by the bite of an Ixodes spp tick, transmission via blood transfusion has been described in humans,9 so dogs and cats that donate blood should be tested for infection prior to donation.10 Because of the shared Ixodes spp tick vector, concurrent infection with Borrelia burgdorferi has been reported in dogs and cats and may contribute to more severe clinical manifestation than either infection alone.11-15
Geographic distribution of anaplasmosis follows that of the tick vector, and the seroprevalence of A phagocytophilum in dogs and cats varies by region.2,4,12,15-18 Anaplasmosis has been reported with highest incidence in the midwest, northeast, and western United States.2,16 Infection has also been reported in Canada, Europe, Asia, and South America, although more studies are needed to understand vector transmission in areas not endemic for Ixodes spp.3,4,6,17,19-24
Risk for exposure and/or infection is increased in animals that live in an Ixodes spp-endemic area, receive acaricidal medications inconsistently, and have increased outdoor access, particularly to natural tick habitats. Transmission to mammals occurs within 24 to 48 hours of tick attachment.25,26 Disease prevalence corresponds with increased Ixodes spp tick activity and is therefore highest in the late spring and autumn. Seropositive prevalence is increased in older dogs and cats, as these animals have had more years of exposure.1,7,12,19 Prevalence of exposure to A phagocytophilum and incidence of clinical disease are not equal. Most dogs that test positive for A phagocytophilum infection have no history of clinical illness, and cats that test positive for A phagocytophilum serum antibodies may not have signs of clinical disease.12,27 This discordance complicates testing and confirmation of disease.
History
Dogs and cats are often presented within 2 to 3 days (range, 1-14 days) of onset of signs. Acute lethargy, malaise, and decreased appetite are the most common clinical signs on presentation,2,7,19,20,28-30 with signs of lameness, circling, vomiting, and epistaxis reported less commonly.20,30 Relevant history includes inconsistent or irregular receipt of antiparasitics or acaricides, travel history, and known tick exposure.31-33
Clinical Signs
Clinical presentation is variable and depends on the strain of bacterium and host variables, including immune response and coinfections. Most dogs and cats exposed to A phagocytophilum do not develop disease or develop only mild self-resolving signs, as suggested by experimental infections and high positive serology in the absence of clinical disease.2,12,27,34,35 Animals that do develop clinical illness may show a variety of multisystemic, inflammatory signs but most commonly show nonspecific signs of lethargy, fever, and decreased appetite.1-3,7,19,20,28-30 Lameness or muscle pain, lymphadenopathy, splenomegaly, and, more rarely, neurologic signs of circling, seizures, neck pain, and epistaxis have also been reported.7,20,30
Diagnosis
Making an accurate clinical diagnosis can be challenging, as many dogs and cats that are exposed to A phagocytophilum do not develop clinical disease.12,27 Determining whether an animal’s signs are attributable to active infection requires a multimodal approach to diagnosis.2 Diagnosis of acute granulocytic anaplasmosis should include consistent history and clinical signs, as well as support from CBC results, with direct visual examination of a blood smear, serology testing for specific antibodies, and PCR testing.
The most common abnormalities seen on CBC in dogs are thrombocytopenia, anemia, and leukopenia1,2,19,28,29; these changes are also exhibited in cats, although cats are more prone to platelet clumping and should not be erroneously diagnosed with thrombocytopenia in these cases.7,20 In dogs and cats with acute infection, morulae (ie, clusters of bacteria) can be observed as intracytoplasmic inclusions (Figure 1) on direct examination of a blood smear. When identified, morulae have been reported in as few as 5% and up to 32% of neutrophils.2,7,19,20,29,34 Morulae can also be identified in other affected fluids such as CSF and joint fluid (Figure 2). Serum chemistry results may show nonspecific, inconsistent changes, including increased liver enzymes, hyperbilirubinemia, hypoalbuminemia, and/or hyperglobulinemia.2,20,29

Feline neutrophils containing A phagocytophilum morula. Wright’s stain. Images courtesy of P. Ewing, Angell Animal Medical Center
A number of commercially available serology tests (eg, ELISA, immunofluorescence assay) that assess for specific antibodies against A phagocytophilum surface proteins are readily available, accurate, and cost-effective.35-37 It is important to note that antibodies will be absent or delayed in an acute infection, will appear 14 days postexposure, and will be consistently present 30 days after exposure.35 If a patient is suspected of having granulocytic anaplasmosis but has a negative serology test result, additional testing (eg, conventional or real-time PCR of peripheral blood, recheck serology 4 weeks later) is warranted. A positive test result confirms exposure to the organism and should also be present with clinical signs before making a clinical diagnosis of anaplasmosis. In addition to identifying intragranulocytic morulae on visual examination of a blood smear, identifying bacterial DNA in peripheral blood through PCR testing can confirm the presence of the organism directly in the blood.1,12,38 Peripheral blood can be positive on PCR testing as early as 2 days postexposure and can persist for up to 2 months, even in the absence of clinical signs.34,35,39,40 Antibiotics administered before PCR testing can cause false-negative results for detecting morulae or bacterial DNA in peripheral blood; antibody detection through serologic tests, however, is not affected by previous treatments.2,34,41 In addition to specific testing for A phagocytophilum and a positive response to treatment,20 other causes of clinical signs and clinicopathologic abnormalities should be ruled out to complete the diagnosis of granulocytic anaplasmosis.

Canine neutrophil containing A phagocytophilum morula in inflamed synovial fluid. Wright’s stain
Treatment & Management
Treatment is recommended in any patient that tests positive for A phagocytophilum and also has concurrent clinical signs or clinicopathologic changes that could be consistent with anaplasmosis (eg, thrombocytopenia, intracellular morulae). Treatment with doxycycline (5 mg/kg PO q12h for 14-28 days) is effective in treating most dogs and cats with acute granulocytic anaplasmosis.7,19,20,34,41 Food or water should be given to animals, particularly cats, after doxycycline administration to avoid esophagitis.42 Most dogs and cats respond to therapy within 2 to 3 days, and complete resolution of infection generally occurs in 97% of dogs and 96% of cats.8,20,29,43,44 Treatment is not recommended in patients that are only serologically positive that do not have clinical signs or clinicopathologic changes consistent with anaplasmosis.45 Coinciding immune-mediated conditions have been described and warrant closer monitoring and concurrent treatment with glucocorticoids and supportive care, blood transfusions, and analgesia, as indicated by the patient’s clinical signs.29
Regular tick preventive use is warranted in animals with outdoor access and animals that live in an Ixodes spp-endemic area, as routine use has been shown to significantly reduce the risk for infection.31-33
Prognosis & Prevention
Prognosis is excellent in patients in which disease and/or coinfection is identified and treated early. Patients that have ongoing exposure to Ixodes spp ticks are at risk for re-exposure. Granulocytic anaplasmosis is best prevented by maintaining stringent tick control, reducing exposure to tick habitats, using tick repellents regularly, and having patients screened regularly for ticks after outdoor activity. No vaccines for disease prevention are currently available.
Clinical Follow-Up & Monitoring
Most dogs and cats respond to treatment and have no residual signs that require follow-up. If significant hematologic abnormalities are present, a recheck examination 14 days after initiating treatment is warranted to assess response to therapy. Idiosyncratic hepatic injury secondary to doxycycline administration has been described46; therefore, a serum liver panel obtained 5 to 7 days after initiating treatment may be warranted. If clinical signs persist or a patient is presented with a more complicated condition (eg, immune-mediated hemolytic anemia, immune-mediated polyarthropathy, meningitis) or develops new signs, re-evaluation should be scheduled based on individual patient needs and concurrent condition(s).
Granulocytic anaplasmosis should be included on the differential list for any dog or cat that has been exposed to Ixodes spp ticks and has acute or intermittent signs of lethargy, anorexia, and/or fever and a history of receiving inconsistent tick prevention.